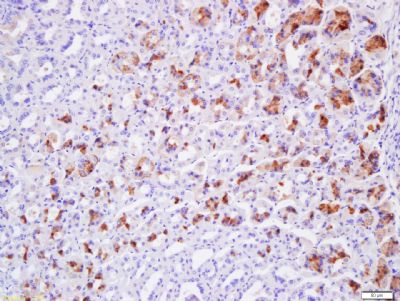
产品细节图片1

相关产品推荐更多 >
万千商家帮你免费找货
0 人在求购买到急需产品
- 详细信息
- 文献和实验
- 技术资料
- 供应商:
上海康朗生物科技有限公司
- 库存:
大量
- 目录编号:
kl-13749R
- 克隆性:
多克隆
- 抗原来源:
Rabbit
- 保质期:
12个月
- 抗体英文名:
Claudin 19 antibody
- 抗体名:
紧密连接蛋白19抗体
- 宿主:
Rabbit
- 适应物种:
Human, Mouse, Rat, Cow, Horse, Sheep,
- 免疫原:
KLH conjugated synthetic peptide derived from human Claudin 19:21-120/224 <Extracellular>
- 亚型:
IgG
- 形态:
冻干粉或液体
- 应用范围:
ELISA=1:500-1000 IHC-P=1:400-800 IHC-F=1:400-800 ICC=1:100-500 IF=1:100-500
- 浓度:
1mg/ml
- 保存条件:
-20 °C
- 规格:
100ul 200ul
| 中文名称 | 紧密连接蛋白19抗体 |
| 别 名 | Claudin 19; CLDN 19; CLD19_HUMAN. |
| 规格价格 | 100ul/1380元 购买 200ul/2200元 购买 大包装/询价 |
| 说 明 书 | 100ul 200ul |
| 研究领域 | 细胞生物 信号转导 细胞粘附分子 |
| 抗体来源 | Rabbit |
| 克隆类型 | Polyclonal |
| 交叉反应 | Human, Mouse, Rat, Cow, Horse, Sheep, |
| 产品应用 | ELISA=1:500-1000 IHC-P=1:400-800 IHC-F=1:400-800 ICC=1:100-500 IF=1:100-500 (石蜡切片需做抗原修复) not yet tested in other applications. optimal dilutions/concentrations should be determined by the end user. |
| 分 子 量 | 23kDa |
| 细胞定位 | 细胞膜 |
| 性 状 | Lyophilized or Liquid |
| 浓 度 | 1mg/ml |
| 免 疫 原 | KLH conjugated synthetic peptide derived from human Claudin 19:21-120/224 <Extracellular> |
| 亚 型 | IgG |
| 纯化方法 | affinity purified by Protein A |
| 储 存 液 | 0.01M TBS(pH7.4) with 1% BSA, 0.03% Proclin300 and 50% Glycerol. |
| 保存条件 | Store at -20 °C for one year. Avoid repeated freeze/thaw cycles. The lyophilized antibody is stable at room temperature for at least one month and for greater than a year when kept at -20°C. When reconstituted in sterile pH 7.4 0.01M PBS or diluent of antibody the antibody is stable for at least two weeks at 2-4 °C. |
| PubMed | PubMed |
| 产品介绍 | background: The Claudin superfamily consists of many structurally related proteins in humans. These proteins are important structural and functional components of tight junctions in paracellular transport. Claudins are located in both epithelial and endothelial cells in all tight junction-bearing tissues. Three classes of proteins are known to localize to tight junctions, including the claudins, Occludin and Junction adhesion molecules. Claudins, which consist of four transmembrane domains and two extracellular loops, make up tight junction strands. Claudin expression is often highly restricted to specfic regions of different tissues and may have an important role in transcellular transport through tight junctions. Claudin-19 is a 224 amino acid multi-pass membrane protein that belongs to the claudin family and is expressed as two isoforms due to alternative splicing events. Defects in the gene encoding claudin-19 are the cause of hypomagnesemia renal with ocular involvement (HOMGO), a renal disease characterized by hypomagnesemia, hypercalciuria and nephrocalcinosis. Function: CLDN19 belongs to the claudin family. It plays a major role in tight junction-specific obliteration of the intercellular space, through calcium-independent cell-adhesion activity. Subcellular Location: Cell junction, tight junction. Cell membrane; Multi-pass membrane protein. Similarity: Belongs to the claudin family. SWISS: Q8N6F1 Gene ID: 149461 Database links: Entrez Gene: 149461 Human Omim: 610036 Human SwissProt: Q8N6F1 Human Important Note: This product as supplied is intended for research use only, not for use in human, therapeutic or diagnostic applications. |
| 产品图片 | ![]() Tissue/cell: mouse stomach tissue; 4% Paraformaldehyde-fixed and paraffin-embedded; Antigen retrieval: citrate buffer ( 0.01M, pH 6.0 ), Boiling bathing for 15min; Block endogenous peroxidase by 3% Hydrogen peroxide for 30min; Blocking buffer (normal goat serum,C-0005) at 37℃ for 20 min; Incubation: Anti-claudin-19 Polyclonal Antibody, Unconjugated(bs-13749R) 1:200, overnight at 4°C, followed by conjugation to the secondary antibody(SP-0023) and DAB(C-0010) staining |
风险提示:丁香通仅作为第三方平台,为商家信息发布提供平台空间。用户咨询产品时请注意保护个人信息及财产安全,合理判断,谨慎选购商品,商家和用户对交易行为负责。对于医疗器械类产品,请先查证核实企业经营资质和医疗器械产品注册证情况。
文献和实验STM:广州医科大学刘铭/谢茂彬合作发现肝细胞癌的新潜在治疗靶点 Claudin 6
组于 Science Translational Medicine 杂志(STM)在线发表题为 Targeting tumor lineage plasticity in hepatocellular carcinoma using an anti-CLDN6 antibody-drug conjugate 的研究论文。这项研究揭示了细胞紧密连接(tight junction)蛋白 Claudin 6 通过调控肝癌细胞的谱系可塑性(lineage plasticity),促进肝癌进展与耐药的机制,并初步报道
thresholds for antigen receptors and other surface receptors on B cells; also regulates B cell development, activation and differentiation CD19 antibody inhibits B cell activation from anti-immunoglobulin Coreceptor with CD21 Earliest B cell
There are a number of disadvantages with conventional tissue immunohistochemistry for accurate �localisation of claudin proteins. Traditionally, tissue cryopreservation or formaldehyde fixation with wax embedding is utilised
技术资料暂无技术资料 索取技术资料